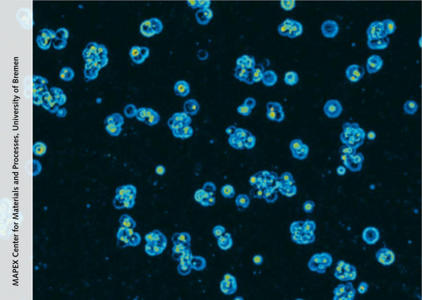

Infos for students
- Admission regulations (in German)
- Examination Regulations of the University of Bremen (in German)
- ProMat-specific Examination Regulations (in German)
- Course schedule (in German)
- Module catalogue with module descriptions (in German)
- Electronic module catalogue (Winter Semester 25/26) (in German)
- Electronic module catalogue (Summer Semester 25) (in German)
- Courses for the foundational module on mathematics(in German)
- Courses for the foundational module on physics(in German)
- Courses for the foundational module on chemistry (in German)
- Courses for the foundational module on computer science tools (in German)
- Courses for the foundational module on engineering (in German)
- Courses for the module of theory-oriented specialization (in German)
- Courses for the module of application-oriented specialization (in German)
Course catalogue with all modules (in German)
- Individual curriculum - Part A, B and C: definition of the individual research focus, mentoring agreement, proposed curriculum (in German)
- Individual curriculum - Part D: Request for changes in the proposed curriciulum (in German)
- Individual curriciulum - Part E: individual exam plan (in German)
- Individual curriculum - Part F: Learning Agreement for the research stay abroad (in German)
- Individual curriciulum - Part G: Application for admission to the Master's thesis (in German)
- Registration for module examinations (in German)
- Record of academic achievements (grade report) (in German)
- Report of results for the Master's thesis (in German)
- Report on the colloquium for the Master's thesis (in German)
- Exam and grade recognition (in German)
- Guideline for ProMat reflection talks (in German)
- Informations on the mentoring concept (in German)
- Informations on the examination registration procedure (in German)
Summer semester 25: 01.04.2025 - 30.09.2025 Course/Lecture period: 07.04. - 11.07. |
Winter semester 25/26: 01.10.2025 - 31.03.2026 Course/Lecture period: 13.10. - 30.01. |
Individual Curriculum Submission date (1st semester):
Submission date for changes:
|
Registration for exams for the winter semester: until 10.1. |
Programme director: | Programme coordination: | ||
Prof. Dr.-Ing. Lucio Colombi Ciacchi | Dr. Enis Bicer +49 421 218 64585 | Britta Hinz hmisekrprotect me ?!uni-bremenprotect me ?!.de +49 421 218 64570 | Dr. Hanna Lührs |
Module Leaders: | |
Module Physics | |
Module Chemistry | |
Module Mathematics | |
Module Computer science tools | Prof. Dr.-Ing. Lucio Colombi-Ciacchi |
Module Engineering | |
Module Theory-based specialization | |
Module Application-oriented specialization |
|
Module Research processes | |
Module Research stay abroad |
|
- Information for students from the University of Bremen
- University of Bremen's Course catalogue
- StudIP: Registering for lecture
- ZPA:Central Examination Office
- PABO: Online exam registration
- Onlinetools: E-Mail, Eduroam, etc.
- Sophos: free antivirus software
- Software for students at the Faculty 4 - Production Engineering, University of Bremen
- Studentenwerk Bremen: Student support
- Bremen erleben: Bremen tourist board
Study profile
| Title: | Master of Science, M. Sc. |
| Length of study: | 4 semesters, 120 CP / ECTS |
| Programme language: | German and English |
| Application deadline: | 15th of January for the summer semester;
|

![[Translate to English:] Zur Startseite des Bereichs Masterstudiengang Prozessorientierte Materialforschung](/fileadmin/user_upload/fachbereiche/studiengaenge/promat/ProMat_-_Photo/Logo/ProMat_RZ_web_rot.jpg)